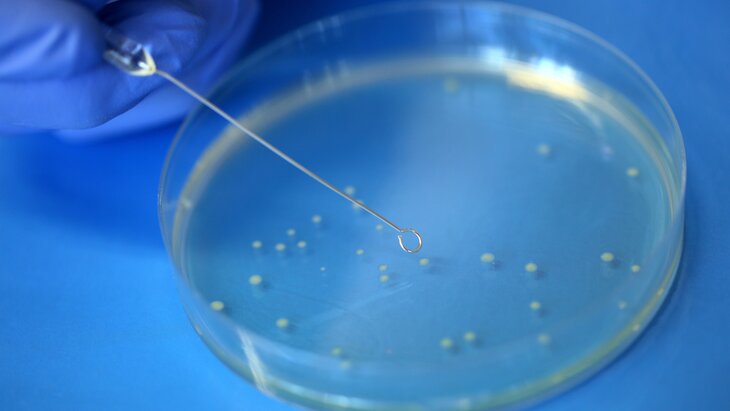

19 апреля 2020, 03:16
ОбществоВирусолог назвал сроки победы России над COVID-19
Фото: Zuma/TASS/Anto Magzan
Стало известно, когда Россия сможет одержать победу над коронавирусной инфекцией COVID-19. Об этом рассказал руководитель лаборатории геномной инженерии МФТИ, вирусолог Павел Волчков.
По мнению специалиста, количество новых случаев заражения будет стремиться к нулю уже в начале лета. Для такого развития событий необходима сознательность граждан в соблюдении режима самоизоляции.
"Это в наших руках. Важно, чтобы мы все сидели дома", – сказал Волчков в интервью RT.
Он отметил, что для эффективности введенные ограничительные меры должны длиться минимум четыре недели. Это обусловлено инкубационным периодом COVID-19, который длится две недели.
"От нас с вами многое зависит, потому что один инфицированный человек заражает десять новых", – подчеркнул вирусолог.
Волчков добавил, что наибольший риск заразиться коронавирусом имеется в закрытых, плохо проветриваемых помещениях.
"Выходя на улицу, надевайте маску, соблюдайте дистанцию. Чем больше – тем лучше", – добавил специалист.
Ранее пульмонолог рассказал о необычных симптомах проявления COVID-19. своим предположением поделился заведующий кафедрой пульмонологии Сеченовского университета, профессор Сергей Авдеев.
По последней информации, в России за сутки зафиксировали 4 785 новых случаев заражения COVID-19. В Москве общее число зараженных составило 20 754.
В Подмосковье число больных коронавирусом выросло за сутки на 428








Собянин вручил городские и государственные награды в преддверии Дня России















